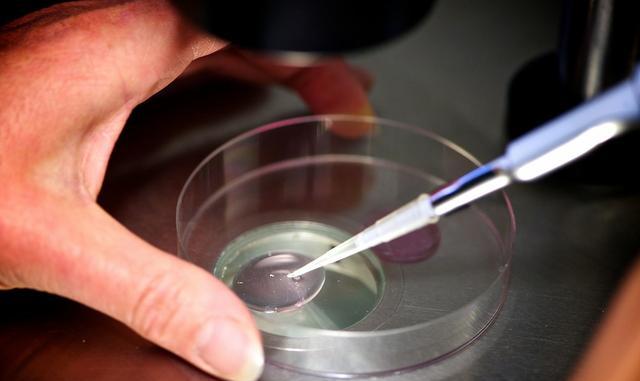
真实案例;36岁试管成功,喜获第二胎

三代香港试管婴儿生龙凤胎的操作流程?
800x524 - 116KB - JPEG

台湾试管婴儿生儿子\/龙凤胎流程大概是怎么样
534x434 - 65KB - JPEG

马来西亚选择做试管婴儿生龙凤胎流程和费用
900x573 - 207KB - JPEG

香港试管婴儿生男女孩,生双胞胎,生龙凤胎费用
450x300 - 96KB - JPEG

内地人到香港做试管婴儿选择性别生龙凤胎的费
260x200 - 21KB - JPEG
真实案例;36岁试管成功,喜获第二胎
640x381 - 23KB - JPEG

泰国试管婴儿生双胞胎男孩(龙凤胎、女孩)费用
300x350 - 155KB - JPEG

66岁印度老妪生试管三胞胎 成最高龄多胞胎母
540x396 - 139KB - JPEG

有没有试管第一次因胎停失败,第二次移植成功
450x337 - 24KB - JPEG

泰国试管婴儿生龙凤胎成功率高吗?_泰嘉运黄
989x703 - 223KB - JPEG

泰国试管婴儿生龙凤胎的费用多少钱_安医生_
800x343 - 85KB - JPEG

去泰国做试管婴儿生多胎有什么风险?-搜狐
600x257 - 36KB - JPEG

试管龙凤胎早产 医生急中生智托起母子平安_
350x262 - 15KB - JPEG

生男生女生选性别,去泰国做试管婴儿生龙凤胎
590x418 - 45KB - JPEG

试管婴儿可以生龙凤胎吗,内地人去泰国做试管
400x385 - 81KB - JPEG
简介:不少夫妇想唤醒冷冻胚胎来生二胎。那什么是冷冻胚胎呢?试管婴儿过程中,通常会同时培养多个胚胎以供移植,剩
其实我一直觉得比姐妹们幸运的多,第一胎是自然生育,第二胎一次试管便成功,我知道做试管的姐妹们要承受多少的痛苦,很不容易,也希望自己的好孕能够传给你们吧。 查看更多
在我国又称第二代试管婴儿。对于因精子数量或者功能异常不孕的夫妇,通过这种方法来 经过慢速(第2~3天的胚胎)和快速 (第5~6天的囊胚)两种降温方式使胚胎能静止下来并
我去年十一月第一次试管移植的鲜胎失败了,这个月底准备第二次移植,直接移植冻胎,好害怕又失败?有经验的姐妹给些建议我去年十一月第一次试管移植的鲜胎失败了,这个. 还
您的情况考虑是试管婴儿的情况 意见建议:您好,你的情况一般情况考虑是这种情况休息3个月后是可以正常排卵的 问今天去医院准备移植冻胚,没想到被告知三个冻胚全解冻不好
有痰,移植后去内科医生给开了三天的阿奇,服用第二天症状明显好转,请问会影响着床吗 问题分析:您好,根据您的以上这些内容的描述,您的情况考虑是试管移植后感冒,防止流产
试管婴儿虽然能解决部分不孕人群生育问题,但不是能保证百分百成功方 法, 就算是试管婴儿移植后成功怀孕了, 也有可能因很多原因而致流产, 引起流 产的原因除孕卵异常、前
采用的生殖辅助技术。“试管婴儿”并不是真正在试管里长大的婴儿,而是从卵巢内取出 体外显微授精胚胎移植技术(俗称第二代)适用于极度少精,弱精患者,用以上的方式(俗称第
病情分析: 不可以的,月经干净3天后空腹检查(男方禁欲3-7天),做试管婴儿,男方需化验精 但是不要起床.可以斜倚在床上.48小时内不要洗澡 ,移植第二天数,第14天的时候去医院